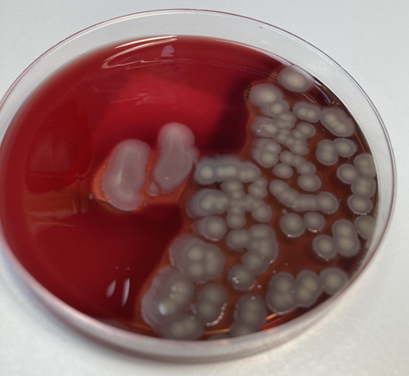

The Grass is Greener: Cow preference for multi-species swards
Effect of multispecies grazing swards on phytochemicals in milk
Two groups of cows will be grazed for 1-month long periods in paddocks of two different sward types: perennial ryegrass monoculture (PRG) and a multi-species sward (MSS) comprising of PRG, timothy, white and red clovers, chicory, and plantain. The Grass Is Greener project will assess cow behaviour on these different sward types and evaluate any impacts on cow welfare via leg mounted accelerometers, fitted on all cows as standard farm practice.
Between these month-long grazing periods, all cows will be given the choice of both sward types (MIX), with their behaviour and welfare being assessed again, as well as their location recorded (PRG or MSS) to assess preference.
The Grass Is Greener project would collect additional data from an existing European funded grazing project, Re-Livestock, taking place at SRUC’s Barony campus.
Effect of multispecies grazing swards on phytochemicals in milk
Effect of multispecies grazing swards on phytochemicals in milk
test test test
Supporting the BVD eradication in Scotland by validation of tests to discriminate BVDV type 1, BVDV type 2 and Border Disease Virus.
Supporting the BVD eradication in Scotland by validation of tests to discriminate BVDV type 1, BVDV type 2 and Border Disease Virus.
Bovine viral diarrhoea (BVD) is a major cattle disease caused in the UK by BVD virus type 1 (BVDV1). Other livestock pestiviruses (BVDV type 2 and Border Disease Virus) can also infect cattle. BVDV1 generally causes mild clinical signs, however abortion, stillbirth and birth of persistently infected (PI) calves can also occur. BVDV2 outbreaks in BVD-free herds carry more severe consequences. Scotland’s BVDV eradication programme, started in 2012, has reduced the number of infected animals significantly, but dairy herds remain particularly affected by BVDV. BVDV2 infections must be reported ‘as soon as possible’ to APHA, however current large scale diagnostic tests do not distinguish between these pestiviruses. A Moredun in-house test can differentiate the three viruses, however validation is required for use with eartags. We intend to validate this and other PCR-based assays and produce a report to allow informed policy decisions on BVDV testing in Scotland.
Vaccine antigen selection for Ostertagia ostertagi.
Vaccine antigen selection for Ostertagia ostertagi.
Parasitic worm infections in dairy cattle is often considered a first grazing season problem, however sub-clinical infections in lactating animals can negatively impact milk production. Currently parasitic nematodes in dairy cattle are controlled using drugs, however long-term use of these drugs has resulted in worm resistance, making the treatments less-effective. Long-term, vaccination against these parasites will provide a means of effective and sustainable parasite control. This project will use high-throughput screening of parasitic worm proteins to identify potential vaccine candidates. The screen will identify worm proteins that are recognised by dairy cattle that show resistance to parasite challenge and assess their potential for incorporation into a vaccine. This work will lead the way to the development of a worm-vaccine to protect dairy cattle against parasitic worm challenge.
Identifying contagious strains of Streptococcus uberis to inform herd health interventions.
Identifying contagious strains of Streptococcus uberis to inform herd health interventions.
Bovine mastitis persists as one of the most important challenges to the dairy industry, estimated to result in annual costs of €20 billion. Streptococcus uberis is a leading cause of bovine mastitis worldwide and in Scotland it is the second most common cause of both clinical and subclinical cases (1). Traditionally, S. uberis has been classified as an ‘environmental’ mastitis pathogen, primarily spreading through indirect means via environmental contamination. However, emerging evidence challenges this model, suggesting that certain strains exhibit contagious transmission characteristics and may be adapted for cow-to-cow transmission. Despite this recognition of contagious spread, there remains a gap in our understanding of the genetic and mechanistic basis of this distinct transmission, and the lack of reliable diagnostic tools for identifying such strains. Addressing these knowledge gaps holds promise for new interventions in bovine mastitis management, potentially reducing the impact of S. uberis on food production, enhancing animal welfare, and reducing the use of antimicrobials.
The fungal milk microbiome of dairy cattle and its implications on mastitis
The fungal milk microbiome of dairy cattle and its implications on mastitis
Fungi are a known cause of mastitis in cattle. Despite this, fungal milk communities associated with development of intramammary infections are under researched. Mastitis is one of the most common and costly diseases in dairying. Commonly, broad-spectrum antibiotics are used in treatment and may lead to an unbalanced milk microbial community (microbiome), potentially allowing for overgrowth of mastitis-causing fungi. This research aimed to explore the microbiome associated with healthy and mastitic (clinical and subclinical) milk, with a focus on fungi and bacterial-fungi interactions, and implications of repeated antibiotic usage.
This project assessed the association between the milk microbiome and mastitis, by sampling milk from healthy (H, n = 10), subclinical mastitis (S, n = 10), clinical mastitis (C, n = 12), and repeated clinical mastitis cases (R, n = 10) in lactating Holstein Friesian cattle. Samples were cultured and DNA metagenomic shotgun sequenced.
Identifying critical control points for colostrum contamination and Mycoplasma prevalence in first milking colostrum from Scottish dairy herds.
Identifying critical control points for colostrum contamination and Mycoplasma prevalence in first milking colostrum from Scottish dairy herds.
Colostrum fed to newborn Scottish dairy calves is highly contaminated. Bacteria in colostrum have the potential to cause disease and prevent calves from absorbing antibodies from their gut after birth, so calves are more likely to get sick and to die. Bacterial contamination may come from a number of different sources including the: cow’s udder, collection bucket, storage bucket and calf feeder. It is important that buckets and feeders are scrupulously cleaned after every use, but many farmers fail to do this. The project aims to identify the main source of contamination for first milking colostrum to allow farmers to focus their attention on these ‘critical control points’ which will have implications for calf health and welfare. In addition, the prevalence of Mycoplasma which causes significant disease in newborn calves will be ascertained. Recent UK work has focussed on bulk milk samples and concluded that contamination is low, but prevalence in colostrum is unknown.
The development of ruminant mammary organoids to facilitate the study of mammary gland biology in vitro
The development of ruminant mammary organoids to facilitate the study of mammary gland biology in vitro
Intramammary infections of ruminant livestock impact animal health, welfare, and the economics of the dairy industry worldwide. A major hurdle to studying the ruminant mammary gland is the lack of in vitro tools to perform research on the mammary response to infection under laboratory conditions. Here, we propose to develop ruminant derived three-dimensional culture models (“organoids”) which represent the internal cellular structure of the mammary gland. Firstly, we will establish a tissue bank from non-lactating and lactating sheep and cow at different ages and various stages of the lactation cycle. Secondly, we will identify a panel of ruminant epithelial cell-type specific antibody markers using the tissue sections from lactating and non-lactating cows and sheep. Thirdly, we will use the panel of basal and luminal epithelium-specific antibody markers to define the structural and cellular organization in mammary epithelial organoids. We will induce lactation by hormonal stimulation of the organoids and characterize the response by gene expression and proteomic analysis. Finally, we will demonstrate the utility of ruminant mammary organoids as a model for intramammary bacterial infection. This will provide a well characterized laboratory tool in support of the development of new mastitis control measures.
The improvement of health and performance of dairy-bred calves on a calf rearing unit through strategic grouping
The improvement of health and performance of dairy-bred calves on a calf rearing unit through strategic grouping
The dairy-beef sector has increased markedly in the UK due to the use of sexed dairy semen as not all cows within the dairy herd will be needed to breed replacement dairy heifer calves. The majority of these dairy-bred calves will enter the dairy-beef production cycle by being sold onto calf rearing units at a young age. At such rearing units, these calves will enter an unfamiliar environment and potentially be mixed with other calves from other farms. These all present a challenge to such calves. The initial objectives of this study were to:
- assess the respiratory health of dairy-beef calves, sourced from a collection of dairy farms, on arrival at a commercial rearing unit
- assess the impact of different grouping strategies, based on health assessments or normal farm practice, on calf health and performance outcome
However, due to concerns regarding the physical movement between pens, combined with the handling of calves to allow measurements to occur and an extended period of extremely high environmental temperatures for the geographical location, all of which were stressors on the calves, it was decided that the calves would remain in the groups in which they arrived, and any assessment of grouping strategy would be done on reflection but no physical mixing of calves. Any grouping would still be based on the arrival clinical and respiratory health.
Calf management: The effect of single and paired housing on dairy calf health and welfare
Calf management: The effect of single and paired housing on dairy calf health and welfare
There have been a number of welfare concerns raised about the individual rearing of dairy calves in early life, such that the practice is now not allowed for many Scottish dairy farmers under a number of supermarket-aligned contracts. Using a non-randomised control trial, this project will examine the effects of individual versus pair-rearing of dairy calves on calf productivity (assessed via daily liveweight gain), health (morbidity and mortality) and welfare assessments (assessed using a number of behavioural measures including latency to feed, novel object test and Qualitative Behavioural Assessment (QBA) as well as salivary cortisol measurements). The hypothesis is that pair-rearing dairy heifer calves from birth to 2-3 weeks of age compared to individual rearing will provide long-term benefits in calf performance, health and welfare.